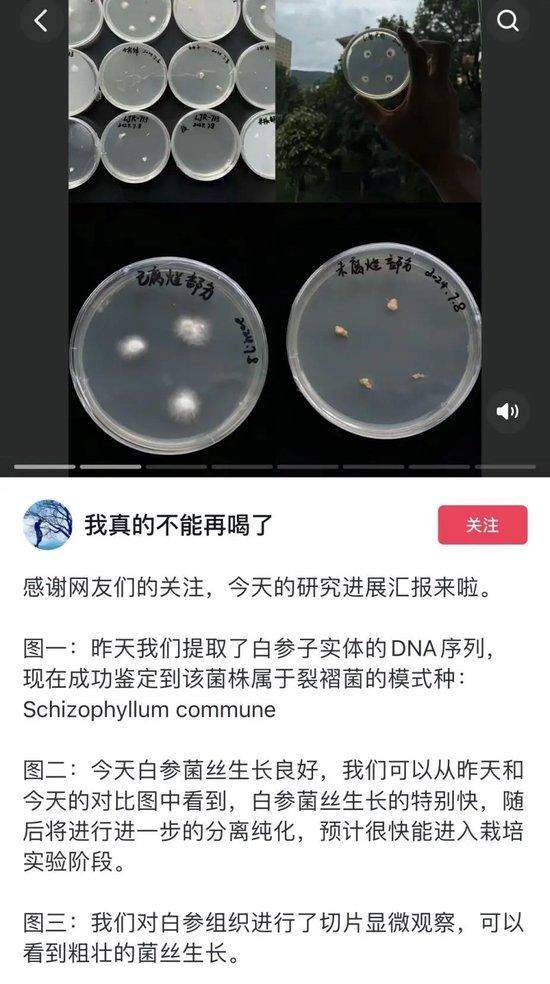
长蘑菇的苹果意外成网红,专家:这菌子能吃!

连绵不绝的梅雨季里
浙江网友@LYN-沛容 发现
家里的苹果居然长蘑菇了!

网友看个乐
科研人员却看到宝了
才过了4天
中国科学院昆明植物研究所
的许博士找到博主
这颗苹果就通过生鲜冷链
从浙江寄到了云南
开始了它奇妙的科研之旅

网友们“看着这颗苹果长大”
许博士也不负期待
在抖音求到这份特殊的研究样品后
他每天发好几条视频
记录苹果的近况
苹果上的菌丝是有名的食用菌
——白参菌丝
科研人员首先
对苹果各部位的菌丝进行了分离
到7月10日
未腐烂果肉部分有少量菌丝生长
已腐烂果肉部分菌丝长得最快最好
说明白参的主要营养来源是果肉
菌丝基本养成之后
科研人员开始测序
确定该菌株属于裂褶菌的模式种:
Schizophyllum commune
更有意思的是
现在菌丝长得非常茂密
进一步侵蚀苹果
如果把它放到适宜的温度湿度下
可能还会有新的子实体产生!
7月12日
许博士在抖音给大家汇报
科研人员已经把这颗苹果上的白参菌
接种到了其他新鲜水果上
苹果、桃子、梨……
他拿起一盒已腐果肉上的菌丝
夸赞“长势非常漂亮”
菌包也在准备中了
下一步就是种植
他还晒出羊肚菌的培育照片
并表示
“希望‘苹果菇’也能
像我们的羊肚菌这样茁壮成长”

科普创作者@植物眼
也立刻采访了许博士的导师——
昆明植物研究所高级工程师赵琪老师
赵老师给大家科普:
“苹果蘑菇”没有苹果味
白参菌也会在人的肺里生长
它可以食用,但需要筛选没有孢子的才行
网友们纷纷追更上头
“这是我参与最深的一次科研项目”
“想吃苹果味的蘑菇”

#关于一颗苹果长蘑菇的事情#
#果菌王被中国科学院专家收了#的话题
也冲上抖音热榜
据昆明植物研究所初步推断
菌子是从苹果的果柄长出来的
白参的生命力极其旺盛
所以从浙江千里迢迢来到云南
也丝毫不减“风采”
而白参之所以顽强
是因为它分解木质素的能力非常强
只要有木质素、温度湿度适宜
它就可以生长和繁殖
南方的梅雨季正好创造了这样的条件
白参也是全球分布最广的真菌、食用菌之一
自然情况下,白参菌从匆匆播种到采收
最快20天就长出来了!

赵琪老师还提起
我国曾将在地面选育后的白参菌丝送上太空
因为野生状态下白参很韧,不好嚼
送上太空是为了培育孢子更少
吃起来更脆的菌子
除了食用性
苹果上长菌子这件事
也提醒了果农
种植过程中一定要做好防范
在云南,白参菌很受欢迎
比如香喷喷的白参炒蛋
所以科研人员在选育更好的白参
满足我们的口腹之欲的同时
还能保证健康

网友们边追更苹果的“奇幻漂流”
边拿出自己生活中遇到的菌子
向许博士请教
芒果、梨、草莓长出菌子不算
有网友刷干净的鞋子也会长菌
竹子、木头更是经常冒出“小惊喜”

大家发现
原来生活中被万般嫌弃的霉菌
不只是生物的变质腐烂
其实也是另一种生命的诞生
一颗苹果在抖音的流动
也是知识在大众的流动
学术研究可以走进大众
知识分享也不必深居象牙塔
短视频正连接起专业与非专业领域
让更多人在
提问、分享、交流的氛围里获益









